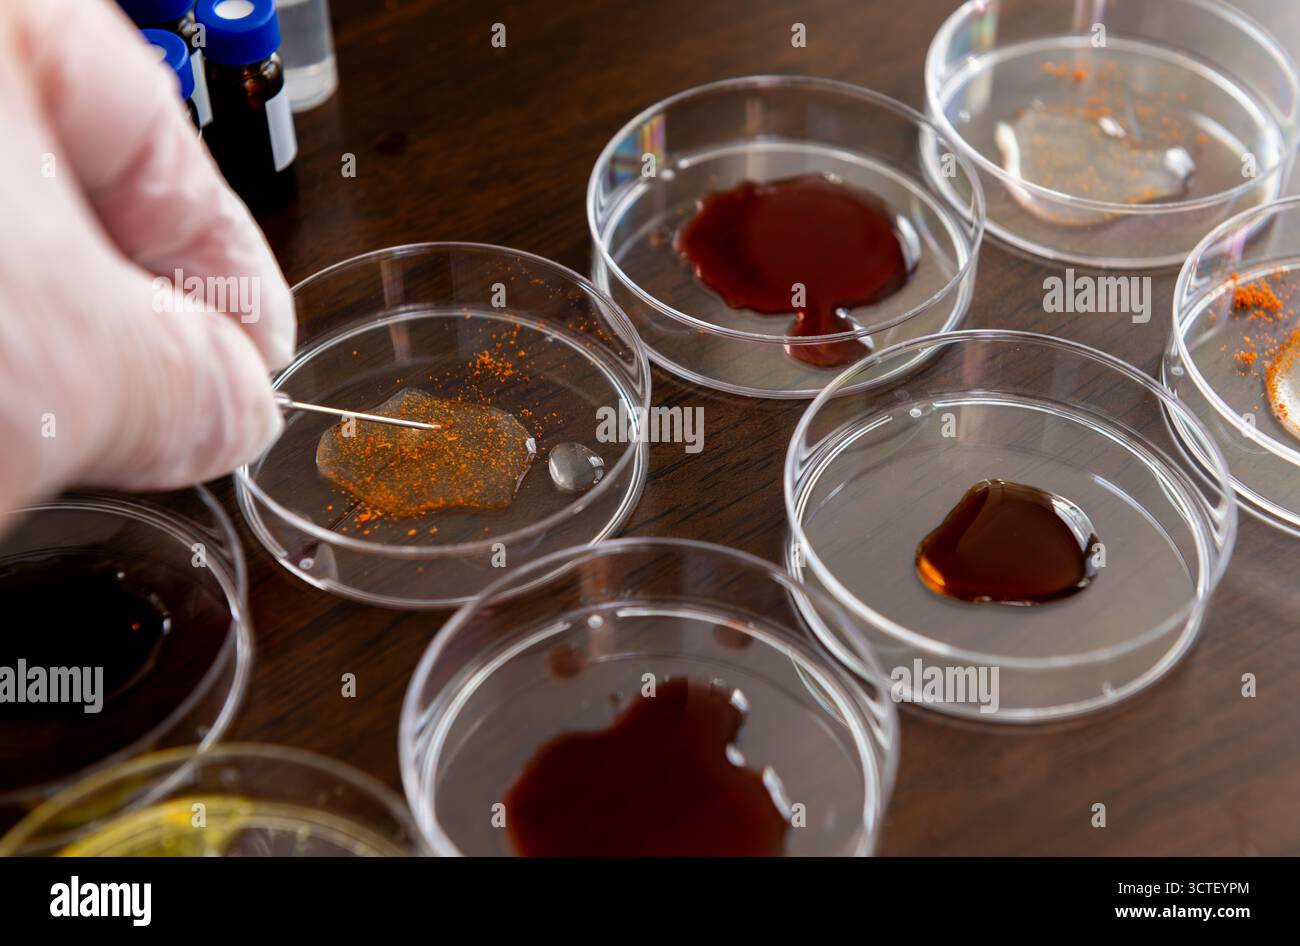
Chercheur dans une expérience de laboratoire utilisant une aiguille pour mélanger des échantillons dans des boîtes de Pétri disposées en rangées sur un plateau de table. Banque D'Images

Chercheur dans une expérience de laboratoire utilisant une aiguille pour mélanger des échantillons dans des boîtes de Pétri disposées en rangées sur un plateau de table.
RFID:ID de l’image:3CTEYPM
Détails de l'image
Contributeur:
Yau Ming LowID de l’image:
3CTEYPMTaille du fichier:
118,3 MB (1,8 MB Téléchargement compressé)Autorisations:
Modèle - non | Propriété - nonUne autorisation est-elle nécessaire?Dimensions:
7920 x 5221 px | 67,1 x 44,2 cm | 26,4 x 17,4 inches | 300dpiDate de la prise de vue:
5 octobre 2025